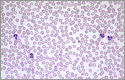

血液の基礎
血液は特殊な体液です。 血漿、赤血球、白血球、および血小板:それは四つの主要なコンポーネントを持っています。, 静脈、動脈、毛細血管を通る血液は、全血として知られており、約55%の血漿と45%の混合物である。パーセント血液細胞。 あなたの総体重の約7から8パーセントは血である。, 平均的なサイズの男性は彼の体に約12パイントの血液を持っており、平均的なサイズの女性は約ナインパイントを持っています。
血液の成分とその重要性
多くの人々が血液検査や献血を受けていますが、血液学-血液の研究-はこれ以上のものを含んでいます。 血液学を専門とする医師(血液学者)は、血液疾患の治療と予防において多くの進歩をリードしています。,
あなたまたはあなたが気にしている人が血液疾患と診断された場合、あなたのプライマリケア医師は、さらなる検査および治療のために血液専
血漿
血液の液体成分は、水、砂糖、脂肪、タンパク質、および塩の混合物である血漿と呼ばれる。 血漿の主な仕事は、栄養素、老廃物、抗体、凝固蛋白質、ホルモンなどの化学メッセンジャー、および体の体液バランスを維持するのに役立つタンパク質と共に、体全体に血液細胞を輸送することです。,
赤血球(赤血球または赤血球とも呼ばれる)
明るい赤色で知られている赤血球は、血液中で最も豊富な細胞であり、その体積の約40-45%を占 赤血球の形状は、平らな中心を有する両凹円盤である-言い換えれば、円板の両方の面は浅いボウル状のくぼみを有する(赤血球はドーナツのように見える)。
赤血球の産生は、主に腎臓によって産生されるホルモンであるエリスロポエチンによって制御される。, 赤血球は骨髄の未熟なセルとして始まり、成熟のおよそ七日後に血流に解放されます。 他の多くの細胞とは異なり、赤血球は核を持たず、簡単に形状を変えることができ、体内のさまざまな血管にフィットするのを助けます。 但し、核の欠乏は赤血球をより適用範囲が広くさせるが、また最も小さい血管を通って移動すると同時に細胞の生命を限り、細胞の膜を傷つけ、エネルギー供給を減らします。 赤血球は平均して120日しか生き残りません。,
赤血球にはヘモグロビンと呼ばれる特殊なタンパク質が含まれており、肺から体の残りの部分に酸素を運び、体から二酸化炭素を肺に戻して吐き出すことができるようにするのに役立ちます。 血液は、ヘモグロビンからその色を得る多数の赤血球のために赤く見える。 赤血球から成っている全血の容積のパーセントはヘマトクリットと呼ばれ、赤血球のレベルの共通の測定です。
白血球(白血球とも呼ばれる)
白血球は感染から体を保護します。, 彼らはあなたの血液の約1パーセントを占め、赤血球よりも数がはるかに少ないです。
最も一般的なタイプの白血球は好中球であり、これは”即時応答”細胞であり、全白血球数の55-70パーセントを占める。 あなたの骨髄は常に感染に対する保護を維持するために新しい好中球を作らなければならないので、各好中球は、一日未満の生活をしています。 好中球の輸血は、体内に非常に長く残らないため、一般的に効果的ではありません。
他の主要なタイプの白血球はリンパ球である。, これらの細胞の二つの主要な集団があります。 Tリンパ球は、他の免疫細胞の機能を調節するのに役立ち、様々な感染細胞および腫瘍を直接攻撃する。 Bリンパ球は、細菌、ウイルス、および他の異物を特異的に標的とするタンパク質である抗体を作ります。
血小板(血小板とも呼ばれる)
赤血球および白血球とは異なり、血小板は実際には細胞ではなく、細胞の小さな断片である。, 血小板は、傷害部位に集まり、傷ついた血管の内層に付着し、血液凝固が起こり得るプラットフォームを形成することによって、血液凝固プロセス(または凝固)を助ける。 これは傷をカバーし、血が漏ることを防ぐフィブリンの血塊の形成で起因します。 従ってフィブリンはまた新しいティッシュが形作る最初の足場を形作り、治療を促進する。,しかし、抗血小板療法の進歩により、これらの潜在的に致命的なイベントを防ぐのに役立つ治療法があります。
血小板の数が正常よりも多いと、不要な凝固を引き起こす可能性があり、脳卒中や心臓発作につながる可能性があります。 逆に、通常よりも低い数は、広範な出血につながる可能性があります。,
完全な血球数(CBC)
完全な血球数(CBC)テストは、あなたの血液中の細胞の種類と数、特に赤血球とその割合(ヘマトクリット)またはタンパク質content有量(ヘモグロビン)、白血球、および血小板についての医師の重要な情報を提供します。 CBCの結果は、貧血、感染症、および他の障害のような条件を診断することができます。, 血小板数および血漿凝固試験(プロトンビン時間、部分トロンボプラスチン時間、およびトロンビン時間)は、出血および凝固障害を評価するために使用

あなたの医者はまた、顕微鏡下であなたの血液細胞を見る方法である血液塗抹標本を行うことができます。 正常な血液塗抹標本では、赤血球は、淡い中心を有する規則的な丸い細胞として現れる。 これらの細胞のサイズまたは形状の変化は、血液障害を示唆し得る。
血液細胞はどこから来るのですか?,
血液細胞は造血幹細胞から発達し、高度に調節された造血プロセスを介して骨髄で形成される。 造血幹細胞は、赤血球、白血球、および血小板に変換することができます。 これらの幹細胞は、新生児の臍帯だけでなく、すべての年齢の人々の血液および骨髄中を循環していることがわかります。 すべての三つの供給源からの幹細胞を使用して、白血病、リンパ腫、骨髄不全、および様々な免疫障害を含む様々な疾患を治療することができる。,
詳細はどこで見つけることができますか?
血液疾患および障害についての詳細を学ぶことに興味があるなら、ここにいくつかの助けになるかもしれない他のいくつかのリソースがあります。
血液学、ASH教育プログラムブックからの記事
アメリカ血液学会(ASH)教育ブックは、この分野の専門家によって毎年updatedされ、患者が利用可能な現在の治療オプションに関する記事のコレクションです。 記事は病気のタイプによってここに分類されます。, あなたが特定の血液疾患についての詳細を学ぶことに興味があるなら、私たちはあなたの医者とこれらの記事を共有し、議論することをお勧め
血液に掲載された臨床研究の結果
最新の血液研究の結果については、ASHの公式ジャーナルであるSearchBloodを参照してください。 最近の記事は一般に加入者のログインを必要とするが、アクセス制御された記事inBloodを見ることに興味がある患者は、Blood Publishing Officeに要求を電子メールで送ることによってコピーを得ることができる。,
患者グループ
このセクションには、患者グループおよび情報を提供するその他の組織へのWebリンクのリストが含まれています。